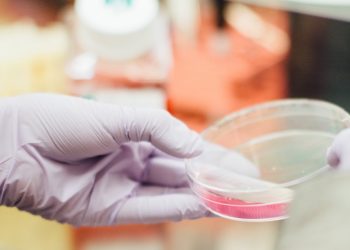

Europe
What's happening in Brussels and what the rest of Europe is up to through the eyes of the Mainland Times. In simple terms, how the current events in the EU will affect the lives of EU citizens and expats.
Braintri signs Benefia deal
Braintri, a European leader in FinTech innovations, has announced a new deal with the Benefia subsidiary of Vienna Insurance Group....
Read moreUkraine and Poland should not give up on Nord Stream 2
On July 21, the United States and Germany issued a joint statement on Nord Stream 2, supporting Ukraine, European energy...
Read morePolish company Biotrem points way to waste-free disposables
Polish brand Biotrem is looking to set an example in the development of waste-free technology with its invention of wheat-bran...
Read moreEnvironmental groups warn Poland not to restart logging in Białowieża Forest
A coalition of environmental groups has criticised moves by the Polish state-owned forestry company to restart commercial logging in the Białowieża Forest...
Read moreITUC: Workers in Belarus, Ukraine have fewest rights
The International Trade Union Confederation (ITUC) has ranked Belarus and Ukraine among the worst countries in Europe which to work...
Read moreTop Huawei employee in Poland arrested for spying
Poland’s Internal Security Agency (ABW) has detained two people on suspicion of cooperating with the Chinese secret services. TVP Info...
Read moreUrsula von der Leyen unveils new European Commission
The president-elect of the next European Commission, Ursula von der Leyen, has named the members of her commission. The new...
Read moreEBRD outlines 2020 priorities for emerging Europe
Improvements in governance can create significant opportunities when it comes to economic growth, the European Bank for Reconstruction and Development...
Read moreWerner Herzog to tell story of Japanese soldier who refused to surrender
Werner Herzog is writing a book about Hiroo Onoda, the Japanese soldier who took three decades to surrender after the...
Read moreTake any coronavirus numbers coming out of emerging Europe with a pinch of salt
On paper at least, emerging Europe has not yet been as badly affected by the coronavirus pandemic as Western Europe....
Read more